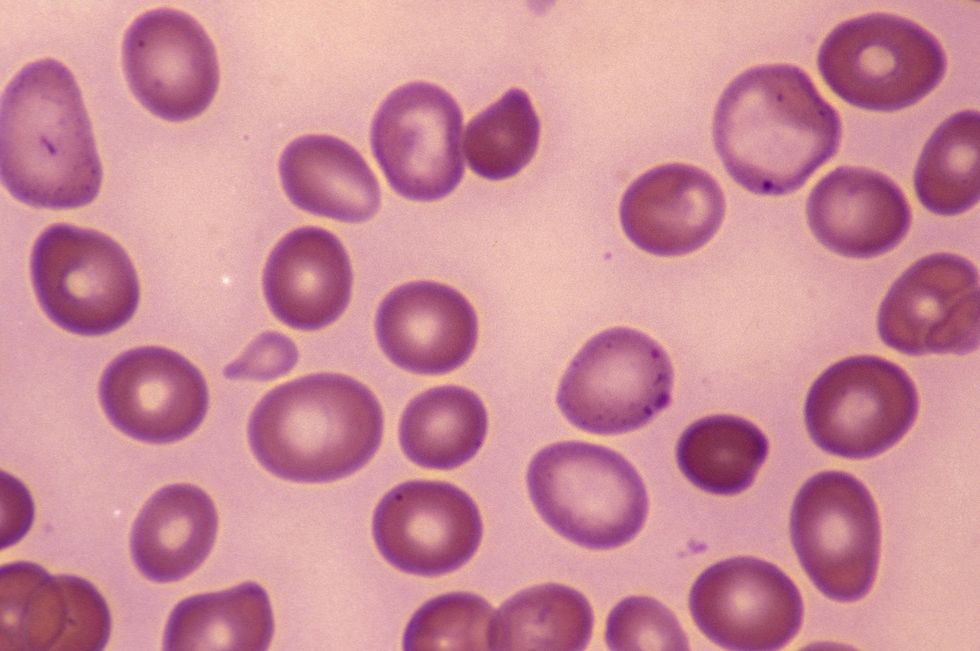

'My B12 deficiency terrifies me - the debilitating symptoms have become so much worse since my diagnosis'
If left untreated, the condition can cause irreparable damage to the body
Don't Miss
Most Read
A B12 deficiency affects around six million people in Britain today, with the condition being more common in older individuals, with around a fifth of those over 60 living with the diagnosis.
However, it can affect younger adults too. Molly, who is known as @mollsandmabel on TikTok, documents her daily life as a single mother as well as her journey to a B12 deficiency diagnosis.
Common symptoms of such a deficiency include loss of appetite, feeling weak or tired, and headaches - all of which affected Molly, who was diagnosed with pernicious anaemia (a B12 deficiency) in 2022.
She explained: "I've been left terrified because, since 2022, my symptoms have never gone away. I was constantly spaced out, forgetful and, at one point, I was actually falling asleep in the middle of the day."

The condition can be treated with tablets or injections
|@mollsandmabel/TikTok
The condition can also cause issues with vision. Molly returned to the doctors after this symptom posed a problem to her care responsibilities.
"The past week that's just gone, I ended up having a headache that was so bad for three days I actually could not see," she shared with followers.
Speaking about her experience with treatment, she found that the injections "definitely did help, but by no means did they cure me".
Over the past six months, her health has deteriorated, and when she assessed her symptoms, she "noticed they were the same as when [she] originally got diagnosed with low B12, except they are now so much worse".
LATEST DEVELOPMENTS
Sharing the various symptoms associated with B12 deficiency (also known as folate deficiency anaemia) she explained that they "really vary from person to person".
As a result, treatment plans can differ between patients. "Some people can just take a tablet, and other people like me may need to have injections," she said.
"But typically the NHS only offers one injection every three months."
She admitted that the injections do help her, but she believed she was not having them "often enough". This means the effects "wear off" before her next jab, causing her to become ill.
Molly was diagnosed with pernicious anaemia in 2022
|GETTY
According to the NHS, symptoms of vitamin B12 deficiency can become worse over time if the condition goes untreated.
Other indicators that Molly did not mention in her video can include shortness of breath, palpitations, diarrhoea, a sore or red tongue, as well as cognitive issues.
Neurological issues can rear their head as well with the vitamin deficiency, such as depression and anxiety, or more physical issues from numbness to problems with balance and coordination.
Diagnosed with a medical assessment and a blood test, it is crucial that a B12 deficiency is identified and treated as quickly as possible.
If left untreated, certain symptoms can be "irreversible", the NHS warned, urging individuals concerned with their health and wellbeing to see their GP if they are worried.










